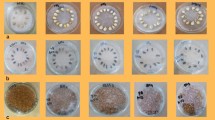

Abstract
Objective
To investigate the biochemical and enzymatic properties of chlorogenic acid hydrolase (ChlH) from Aspergillus niger SD14.721 and its applicability in sunflower seed protein processing.
Results
The ChlH with two identical subunits (97 kDa) was highly stable. Its optimal temperature and pH were determined as 60 °C and pH 7.0. The Km towards chlorogenic acid (CGA) was 1.85 μM. Based on its N-terminal sequence (AVDSVDAIFA), the purified ChlH appeared to be a new chlorogenic acid hydrolase. When applied in sunflower seed protein extraction, ChlH removed 99.13% of CGA in sunflower seed pastes, thus the colour of sunflower seed protein (SSP) changed from green to grey and its visual acceptance improved. Meanwhile, the solubility, water absorption capacity, and emulsification stability of SSP were increased 48.39%, 59.32% and 22.92%, respectively.
Conclusions
A new ChlH was obtained and its feasibility as a CGA-removal tool to obtain high quality SSP was demonstrated.
Similar content being viewed by others
Explore related subjects
Discover the latest articles, news and stories from top researchers in related subjects.Avoid common mistakes on your manuscript.
Introduction
Chlorogenic acid exists as a soluble ester conjugate of quinic acid and hydroxycinnamic acid, such as ferulic, caffeic and coumaric acids (Butiuk et al. 2015) It can be found in coffee, apples and sunflower seeds at high concentrations (Gonzálezpérez et al. 2002). Chlorogenic acid hydrolase (also named as chlorogenic acid esterase, ChlE) has been attracting commercial attention due to its ability to hydrolyze, esterify and transesterify with 2-phenylethyl alcohol to 2-phenylethyl caffeate (Kakino et al. 2003; Kishimoto et al. 2005). The hydrolysis of chlorogenic acid by ChlH also provided a feasible method to prevent quinone formation, since CGA might covalently combine with the polar groups of proteins under alkaline conditions, which forming green trihydroxy benzacridine derivatives results in significant greening of protein (Liang et al. 2017). In addition, ChlH could enhance the flavour of coffee when roasted by reducing the dehydration and cyclization of CGA to generate chlorogenic acid lactones, which have been identified as key contributors to the bitterness of coffee (Kraehenbuehl et al. 2017; Moon et al. 2009).
Some microorganisms that synthesize ChlH have been reported, including Arbuscular mycorrhizal (Negrel et al. 2016), Aspergillus japonicus (Okamura and Watanabe 1982), Aspergillus niger (Asther et al. 2005; Benoit et al. 2007; Schöbel and Pollmann 1980), Aspergillus sojae (Adachi et al. 2008), Rhizoctoina solani (Nieter et al. 2017) and Ustilago maydis (Nieter et al. 2015, 2016). Moreover, there are also other enzymes that have activities towards CGA, such as FABE (Levasseur et al. 2004), TsFaeC (Vafiadi et al. 2006), Fae1A (Qi et al. 2011), AoFaeB and AoFaeC (Koseki et al. 2009). However, most of these enzymes have various defects, such as the low expression and activities of the wild type strains, the poor stability and weak affinity, which makes the enzymes unacceptable for use in industry.
Our previous research on screening microorganism strains with CGA as the sole carbon source, found that a high-performance strain of A. niger SD14 with a CGA hydrolytic activity of 0.048 U/ml, was identified. A. niger SD14.721 (0.081 U/ml) was the most optimal producer of ChlH by using atmospheric and ambient-temperature plasma mutagenesis. In this study, we explored the purification and characterization of the extracellular ChlH from A. niger SD14.721 and its application on CGA hydrolysis during the sunflower seed protein (SSP) preparation.
Materials and methods
Medium and fermentation conditions of A.niger SD14.721
A. niger SD14.721 was obtained from a honeysuckle planting base (Linyi, China) using atmospheric and room-temperature plasma mutagenesis. The GenBank accession number of its gene sequence was KY860764 and it was deposited in the Culture and Information Centre of Industrial Microorganisms of China Universities (Wuxi, China.) numbered F0920. The strain was grown in PDA media and fermented to produce enzymes in medium containing (per litre): 5% (w/v) wheat bran as a hydrolase activity inducer, beef extract (2.1 g) and ammonium sulfate (0.93 g) as a compound nitrogen source, maltose (2.5 g) as a carbon source, KH2PO4 0.2 g, CaCl2·2H2O 0.0132 g, and MgSO4·7H2O 0.5 g. The pH of the liquid medium was adjusted to 6.0, and the strains were fermented at 160 rpm at 25 °C for 11 days.
Biochemical properties of ChlH
Enzyme activity assay
The activity of ChlH was determined by monitoring the CGA decrease at its peak time (8 min) with HPLC (Alliance 2695). The samples (250 μl crude enzyme solution + 100 μl 50 mM phosphate buffer (pH 7) + 650 μl 0.5 mg/ml CGA) were incubated at 60 °C for 15 min and stopped by adding 1 ml methanol. Then the samples were centrifuged, filtered and injected into a Waters Xbrige C18 column (4.6·← 250 mm; Waters Corporate, USA) at 30 °C, and eluted with acetonitrile and 2% acetic aqueous solution at a ratio of 15:85(v: v) with a flow rate of 0.5 ml/min. The elution was monitored by a PDA detector at 327 nm. One unit of ChlH activity was defined as the amount of enzyme that catalysed the hydrolysis of 1 μM CGA per minute at 60 °C in 50 mM phosphate buffer at pH 7 (Buffer A).
Enzyme purification
After 11 days fermentation, the broth of A. niger SD14.721 was filtered and concentrated eightfold by ultrafiltration through a PLCCC membrane (molecular mass cut-off of 5 kDa). The supernatant was then added with ammonium sulfate from 50 to 90% saturation and centrifugated at 5000×g for 30 min at 4 °C. Then, the precipitate was dissolved in 20 mM Tris-HCl buffer at pH 7.5 (Buffer B) and dialysed against the same buffer. For further purification, the dialysed enzyme was applied to a HiTrap DEAE-Sepharose Fast Flow column (0.7·← 2.5 cm; GE Healthcare, USA), equilibrated with Buffer B and eluted with a 0–0.2 M NaCl linear gradient (pH 7.5) at 1 ml min−1 by using the same buffer. The fractions were collected and its activity as well as protein content was assayed. The active fractions were pooled and concentrated to 5 ml. Then the concentrate was applied to a Superdex 200 10/300 GL column (1.0·← 30 cm; GE Healthcare, USA) (Stefan et al. 2018), equilibrated and eluted at a flow rate of 0.4 ml min−1with Buffer B.
Protein analysis
The protein content of enzyme extract was measured according to the Bradford (1976) method with bovine serum albumin as the standard. The purity and the molecular mass were determined by SDS-PAGE electrophoresis (12% resolving gel and 5% stacking gel) (Yang et al. 2018) and size-exclusion chromatography (Superdex 200 10/300GL filtration column). the gel was stained with Coomassie Brilliant Blue R-250. For enzyme protein identification, the first 10 amino acids of the N-terminus were sequenced by Sangon Biotech. Co., Ltd. (Shanghai, China).
Enzyme properties of ChlH
Optimal temperature, pH and stability of ChlH
To explore the optimal temperature, the activity of ChlH was determined at temperature from 20 °C to 80 °C with 50 mM phosphate buffer at pH 7. The thermal stability was evaluated by assaying the residual activity after incubating ChlH at different temperature (20–70 °C) for 30–210 min. Besides, residual activity of the ChlH at 30 °C was assayed at a pH range from 3.0 to 10.0 with a series of buffers, including 50 mM citrate buffer (pH 3.0–5.0), phosphate buffer (pH 5.0–8.0), and glycine–NaOH buffer (pH 9.0–10.0), to determine the optimal pH. The pH stability of ChlH was assayed at the same pH range for 210 min. The enzyme solution without incubation was used as the blank. the reaction was terminated using ice-water bath.
Effect of metal ions on the enzyme activity
The effect of metal ions on ChlH hydrolysis activity was investigated by incubating enzyme solutions at 30 °C for 60 min with 5 mM and 10 mM metal ions, including K+ (KCl), Na+ (NaCl), Ca2+ (CaCl2), Cu2+ (CuSO4), Fe2+ (FeSO4), Mn2+ (MnSO4), Zn2+ (ZnSO4), Mg2+ (MgSO4), Al3+ (AlCl3) and Fe3+ (Fe2(SO4)3) (Song et al. 2018). The enzyme activity without addition of metal ions was used as the control and set as 100%.
Kinetic parameters
The kinetic parameters of ChlH were explored by assaying the initial reaction rates with CGA at 60 °C and pH 7 for 15 min. The Km and Vmax values were calculated using double reciprocal Lineweaver–Burk plots. Different concentrations of CGA from 0.001 to 1 mM were used for enzyme reaction rates assay.
Application of ChlH in the preparation of SSP
Phenol-removal treatments and the preparation of SSP
Unshelled intact sunflower seed was purchased from Mengbiyuan Technology Co., Ltd, Inner Mongolia Autonomous region. The sunflower seeds were treated by two different pre-treatments to remove phenol. (a) AS: 100 g seeds were incubated in 1 mM HCl for 3 h (acid soaking) at a solid/liquid ratio of 1:5 (w:v) at 70 °C. (b) CHAS: After acid soaking, these phenol-removed seeds were dried at 60 °C and ground to pastes. 100 g sunflower seed pastes were incubated in 1 l deionized water with 1 ml purified ChlH (0.5 U/ml) added at 60 °C and stirred at 150 rpm for 3 h.
After three different phenol-removal pre-treatments (untreated, AS and CHAS), the aqueous extraction processing (Li et al. 2016) was applied to extract oil from sunflower seed pastes. The oil extraction processing was carried out at 70 °C and pH 9.0 with seed/water ratio of 1:5 (w/v) for 1 h and the oil yield of 87.12 ± 0.41% was obtained. The SSP was prepared from the defatted sunflower seed meals by extraction with alkali (pH 10.5, 60 °C) for 1 h and precipitation at pH 4.5.
Removal yield of CGA
Sunflower seed pastes after different phenol-removal treatments were soxhlet extracted with methanol at 70 °C for 10 h. The CGA in the extracts was quantified using HPLC at 327 nm.
Functional properties
The solubility of SSPs was evaluated as described by Stephanie and Abdullaha (2009) with minor modifications. A portion of SSP samples (0.20 g) was added to 20 ml 0.2 M phosphate buffer (pH 7.0) and continuously stirred for 30 min. It was subsequently centrifuged at 4000×g for 15 min.
The water absorption capacity (WAC) and fat absorption capacity (FAC) of SSPs were measured as described by Madhusudhan and Singh (1985). 8 ml deionized water or soybean oil was added to 0.20 g protein sample (G1), shaken for 2 min to achieve full adsorption and centrifuged at 6000×g for 15 min. The rest of the sample was weighed without the supernatant (G2).
The determination of the emulsification ability index/emulsification stability (EAI/ESI) of SSPs was based on the method of Pearce and Kinsella (1978). Briefly, 100 mg protein sample was dissolved in 25 ml 0.2 M phosphate buffer (pH 7.0) with 10 ml soybean oil added and quickly whipped at 13500 rpm for 1 min. Immediately, 100 μl emulsion of the bottom was pipetted, and 0.1% (w/v) SDS was added, then the absorbance value of the diluted sample was measured at 500 nm (A0). The emulsified sample was incubated at 30 °C for 60 min and measured (A60) in the same manner as A0. DF was the dilution factor and C was the protein concentration (g/ml).
Statistical analysis
All experiments were carried out in triplicate, and each result was expressed as the mean ± standard deviations (SD). The differences between groups were tested by one-way ANOVA and Duncan’s multiple range tests (SPSS version 19.0) with the level of statistical significance set at p < 0.05.
Results and discussions
Enzyme Purification
The enzyme with CGA hydrolysis activity was purified to homogeneity by four separation steps (Table 1) with a high recovery of 29.26%. Ammonium sulfate precipitation could remove most impurity proteins without significant enzyme activity loss. The fractions eluted from the DEAE-Sepharose FF column contained two major protein peaks (Peak 1 and Peak 2), but only Peak 2 had activity against CGA (Fig. 1). This chromatographic strategy did not separate the enzyme effectively due to the broadening of the peaks. All of the fractions that had CGA hydrolysis activity were pooled and applied to a Superdex 200 10/300GL column to further purify the enzyme based on its molecular size. The specific activity of ChlH was 6.15 U/mg with an increase of approximately 547%. The analysis of SDS-PAGE revealed the purified enzyme to be homogeneous (Fig. 2).
SDS-PAGE analysis of the ChlH during its purification. Lane M: protein molecular size marker; Lane 1: the enzyme in A.niger SD17.421 culture medium; Lane 2: the enzyme solution after ultrafiltration; Lane 3: the enzyme solution after (NH4)2SO4 fractionation; Lane 4: the enzyme after DEAE-Sepharose F.F and Superdex 200 10/300GL chromatography
Molecular mass and N-terminus
The molecular mass of microbial ChlE monomer was in a narrow range of 70–90 kDa, but with quite different aggregation structure (Table 2). For the Superdex 200 10/300GL gel chromatography, a standard curve was established as a linear relationship between the elution volume (EV) and the logarithm of the molecular mass (MW): log10 MW = 0.3842 Ev + 2.4227 (R2 = 0.996). According to this equation, the molecular mass of ChlH in this study was determined as 200 kDa. Relationship between relative mobility (M) and the molecular mass (MW) in the SDS-PAGE analysis was as following: log10 MW = − 1.3372 M + 2.1110 (R2 = 0.993). The SDS-PAGE analysis of enzymes showed a single band after gel separation, and the subunit molecular mass was calculated as 97 kDa (Fig. 2). Therefore, ChlH was a dimer with two identical subunits, which was slightly bigger than that of the monomeric UmChlE of U. maydis (71 kDa) (Nieter et al. 2015) and the tetrameric ChloE of A. niger CBS 513.88 (4 × 60 kDa) (Schöbel and Pollmann 1980). Both its weight and aggregation structure were more similar to the chlorogenic acid hydrolases of A. sojae (2 × 88 kDa) (Adachi et al. 2008) and A. niger BRFM 131 (2 × 80 kDa) (Asther et al. 2005).
Enzyme properties
The enzyme properties of the purified ChlH were shown in Fig. 3. The optimal temperature of ChlH was 60 °C (Fig. 3a), and the optimal pH was determined as 7.0 at 60 °C (Fig. 3c). The enzyme remained stable between pH 3.0–7.0 at 20 °C for 210 min (Fig. 3b). The enzyme was also resistant to change at 20–50 °C (Fig. 3d). Compared to reported ChlEs (Table 2), ChlH obtained in this study also showed relatively better stability. During the subsequent processes of oil extraction (at pH 9.0 and 70 °C for 3 h), the ChlH was inactivated due to pH change.
Enzyme properties of the ChlH. a Temperature optima; b thermal stability; c pH optima; d the pH stability, pH in the range of 3.0 to 10.0 by using 50 mM citrate buffer (pH 3.0 to 5.0), phosphate buffer (pH 5.0 to 8.0) and glycine–NaOH buffer (pH 9.0 to 10.0). e Effect of metal ions on the activity of ChlH. Values are the averages of data from triplicate experiments, with standard deviations shown as error bars
Among all tested metal ions (K+, Na+, Ca2+, Cu2+, Fe2+, Mn2+, Zn2+, Mg2+, Al3+ and Fe3+), none promoted its hydrolytic activity towards CGA. Monovalent metal ions decreased the activity slightly. However, except for Mg2+ and Ca2+, divalent and trivalent metal ions remarkably inhibited the activity of ChlH. These different inhibition effects on enzyme activity could be explained that different metal ions showed different binding abilities to active sites in ChlH, therefore influencing the enzyme structure in different ways. The inhibitions of chlorogenic acid hydrolysis activity by Zn2+, Fe2+ and Al3+ were consistent with the feruloyl esterase from Russula virescens (Wang et al. 2014). The negative effects of Cu2+ (Donaghy and Mckay 1997) and Fe3+ (Yao et al. 2013) on esterase activity were also described previously.
The purified ChlH had a high affinity for its substrate, and obeyed Michaelis–Menten kinetics over the substrate concentration ranging from 0.001 mM to 10 mM. The Km and Vmax values were calculated to be 1.85 μM and 0.38 μM/(mg s) with nonlinear regression using the Lineweaver–Burk plot. The kcat value and the specificity constant (kcat/Km) were 0.49/s and 2.65·← 105/(mol s), respectively. Compared to reported data (Table 2), ChlH had a stronger affinity towards CGA.
The first 10 amino acids of the N-terminus were sequenced at Sangon Biotech. Co., Ltd. (Shanghai, China) and determined to be AVDSVDAIFA. The sequence was submitted to the NCBI database to BLAST (Altschul et al. 1997) with other previously published proteins, and no homologous match was identified. Considering molecular mass, enzymatic properties and kinetic comparisons, the purified enzyme was appeared to be a new chlorogenic acid hydrolase that had not been reported yet.
Application of ChlH in the preparation of SSP
The CGA levels in the sunflower seed pastes after acid soaking and further ChlH treatment were shown in Table 3. After ChlH hydrolysis treatment, the CGA content in sunflower seed were greatly lowered by 99.13%, achieving a nearly complete removal. Previous studies showed that ChlE could hydrolyse other natural substrates, such as coffee pulp and apple marc. The recombinant CholE (0.6 U/g) from A. niger could release all the CGA from coffee pulp after overnight incubation (Benoit et al. 2007), and UmChlE (0.02 U/g) from U. maydis also liberated 68% of the CGA from coffee pulp after an incubation period of more than 20 h (Nieter et al. 2015). Therefore, for sunflow seed paste which containing high amount of oil, the successful attempt of ChlH would widely broaden its potential application value.
The decolouration effects in the prepared SSP after different phenol-removal treatments were shown in Fig. 4. The functional properties of the three SSPs and soy protein isolate, especially the solubility, WAC/FAC and EAI/ESI were compared and analysed (Table 4). The acid soaking progress decrease the concentration of CGA, thereby the concentration of the CGA-protein, and ChlH hydrolysed a portion of the CGA-protein conjugates to increase the solubility of the SSP.
For the first time, the feasibility of using chlorogenic acid hydrolase as a pre-processing method to remove CGA from sunflower seed was demonstrated. The newly industrial application of aqueous extraction processing on oilseed like peanut shows very promising future as a new way for comprehensive usage of both its oil and protein (Li et al. 2016). By applying the ChlH in sunflower seed processing, high-quality SSPs could be recovered using aqueous extraction processing.
References
Adachi O, Ano Y, Akakabe Y, Shinagawa E, Matsushita K (2008) Coffee pulp koji of Aspergillus sojae as stable immobilized catalyst of chlorogenate hydrolase. Appl Microbiol Biotechnol 81:143–151
Altschul SF, Madden TL, Schaffer AA, Zhang J, Zhang Z, Miller W, Lipman DJ (1997) Blast and Psi-Blast: protein Database Search Programs
Asther M, Alvarado MIE, Haon M, Navarro D, Asther M, Lesage-Meessen L, Record E (2005) Purification and characterization of a chlorogenic acid hydrolase from Aspergillus niger catalysing the hydrolysis of chlorogenic acid. J Biotechnol 115:47–56
Benoit I et al (2007) Gene overexpression and biochemical characterization of the biotechnologically relevant chlorogenic acid hydrolase from Aspergillus niger. Appl Environ Microbiol 73:5624–5632
Bradford MM (1976) A rapid and sensitive methods for the quantitation of microgram quantities of protein utilizing the principle of protein dye binding. Anal Biochem 72:248–254
Butiuk AP, Adachi O, Hours RA (2015) Yerba mate as a novel inducer for fungal chlorogenate hydrolase production. Biocatal Agric Biotechnol 4:327–334
Donaghy J, Mckay AM (1997) Purification and characterization of a feruloyl esterase from the fungus Penicilliumexpansum. J Appl Microbiol 83:718–726
Gonzálezpérez S, Merck KB, Vereijken JM, van Koningsveld GA, Gruppen H, Voragen AG (2002) Isolation and characterization of undenatured chlorogenic acid free sunflower (Helianthus annuus) proteins. J Agric Food Chem 50:1713–1719
Kakino Y, Kishimoto N, Iba S, Yoshioka S (2003) Fujita T Enzymatic synthesis of caffeic acid phenethyl ester by chlorogenic acid esterase. The Society for Biotechnology, Japan
Kishimoto N, Kakino Y, Iwai K, Fujita T (2005) Chlorogenate hydrolase-catalyzed synthesis of hydroxycinnamic acid ester derivatives by transesterification, substitution of bromine, and condensation reactions. Appl Microbiol Biotechnol 68:198–202
Koseki T, Hori A, Seki S, Murayama T, Shiono Y (2009) Characterization of two distinct feruloyl esterases, AoFaeB and AoFaeC, from Aspergillus oryzae. Appl Microbiol Biotechnol 83:689–696
Kraehenbuehl K, Page-Zoerkler N, Mauroux O, Gartenmann K, Blank I, Bel-Rhlid R (2017) Selective enzymatic hydrolysis of chlorogenic acid lactones in a model system and in a coffee extract. Appl Reduct Coffee Bitterness Food Chem 218:9–14
Levasseur A, Benoit I, Asther M, Asther M, Record E (2004) Homologous expression of the feruloyl esterase B gene from Aspergillus niger and characterization of the recombinant enzyme. Protein Exp Purif 37:126–133
Li PF, Gasmalla MAA, Zhang WB, Liu JJ, Bing R, Yang RJ (2016) Effects of roasting temperatures and grinding type on the yields of oil and protein obtained by aqueous extraction processing. J Food Eng 173:15–24
Liang S, Were L (2017) Chlorogenic acid induced colored reactions and their effect on carbonyls, phenolic content, and antioxidant capacity in sunflower butter cookies. LWT Food Sci and Technol 87:16–22
Madhusudhan KT, Singh N (1985) Effect of heat treatment on the functional properties of linseed meal. J Agric Food Chem 33:1222–1226
Moon JK, Yoo HS, Shibamoto T (2009) Role of roasting conditions in the level of chlorogenic acid content in coffee beans: correlation with coffee acidity. J Agric Food Chem 57:5365–5369
Negrel J, Javelle F, Morandi D, Lucchi G (2016) Characterization and purification of a bacterial chlorogenic acid esterase detected during the extraction of chlorogenic acid from arbuscular mycorrhizal tomato roots. Plant Physiol Biochem 109:308–318
Nieter A, Haase-Aschoff P, Kelle S, Linke D, Krings U, Popper L, Berger RG (2015) A chlorogenic acid esterase with a unique substrate specificity from Ustilago maydis. Appl Environ Microbiol 81:1679–1688
Nieter A, Kelle S, Takenberg M, Linke D, Bunzel M, Popper L, Berger RG (2016) Heterologous production and characterization of a chlorogenic acid esterase from Ustilago maydis with a potential use in baking. Food Chem 209:1–9
Nieter A, Kelle S, Linke D, Berger RG (2017) A p-coumaroyl esterase from Rhizoctonia solani with a pronounced chlorogenic acid esterase activity. New Biotechnol 37:153–161
Okamura S, Watanabe M (1982) Purification and properties of hydroxycinnamic acid ester hydrolase from Aspergillus japonicus. J Agric Chem Soc Jpn 46:1839–1848
Pearce KN, Kinsella JE (1978) Emulsifying properties of proteins: evaluation of a turbidimetric technique. J Agric Food Chem 26:716–723
Qi M, Wang P, Selinger LB, Yanke LJ, Forster RJ, Mcallister TA (2011) Isolation and characterization of a ferulic acid esterase (Fae1A) from the rumen fungus Anaeromyces mucronatus. J Appl Microbiol 110:1341–1350
Schöbel B, Pollmann W (1980) Isolation and characterization of a chlorogenic acid esterase from Aspergillus niger Zeitschrift Fur Naturforschung Section C-a. J Biosci 35:209–212
Song J, Kim SY, Kim DH, Lee YS, Sim JS, Hahn BS, Lee CM (2018) Characterization of an inhibitor-resistant endo-1,4-β-mannanase from the gut microflora metagenome of Hermetia illucens. Biotechnol Lett 40:1377–1387
Stefan A, Calonghi N, Schipani F, Piaz FD, Sartor G, Hochkoeppler A (2018) Purification of active recombinant human histone deacetylase 1 (HDAC1) overexpressed in Escherichia coli. Biotechnol Lett 40:1355–1363
Stephanie J, Abdullaha M (2009) Low temperature dry extrusion and high-pressure processing prior to enzyme-assisted aqueous extraction of full fat soybean flakes. Food Chem 114:947–954
Vafiadi C, Topakas E, Christakopoulos P, Faulds CB (2006) The feruloyl esterase system of Talaromyces stipitatus: determining the hydrolytic and synthetic specificity of TsFaeC. J Biotechnol 125:210–221
Wang L, Zhang R, Ma Z, Wang H, Ng T (2014) A feruloyl esterase (FAE) characterized by relatively high thermostability from the edible mushroom Russula virescens. Appl Biochem Biotechnol 172:993–1003
Yang L, Zhou N, Tian Y (2018) Purification, characterization, and biocatalytic potential of a novel dextranase from Chaetomium globosum. Biotechnol Lett 40:1407–1418
Yao J, Chen QL, Shen AX, Cao W, Liu YH (2013) A novel feruloyl esterase from a soil metagenomic library with tannase activity. J Mol Catal B Enzym 95:55–61
Acknowledgements
This work was supported by the National High Technology Research and Development Program of China (2013AA102103); the National Natural Science Foundation of China (31401635); and national first-class discipline program of Food Science and Technology (JUFSTR20180202).
Author information
Authors and Affiliations
Corresponding author
Additional information
Publisher's Note
Springer Nature remains neutral with regard to jurisdictional claims in published maps and institutional affiliations.
Rights and permissions
About this article
Cite this article
Zhang, W., Liu, Y., Hu, M. et al. Preparation of high-quality sunflower seed protein with a new chlorogenic acid hydrolase from Aspergillus niger. Biotechnol Lett 41, 565–574 (2019). https://doi.org/10.1007/s10529-019-02654-w
Received:
Accepted:
Published:
Issue Date:
DOI: https://doi.org/10.1007/s10529-019-02654-w